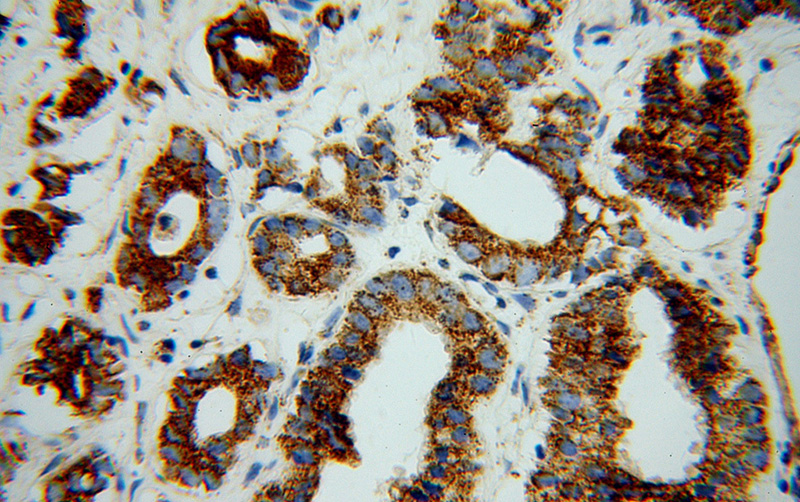
Immunohistochemical of paraffin-embedded human gliomas using Catalog No:111042(GLUD1 antibody) at dilution of 1:100 (under 40x lens)

-
Product Name
GLUD1 antibody
- Documents
-
Description
GLUD1 Rabbit Polyclonal antibody. Positive IHC detected in human gliomas tissue. Positive WB detected in HeLa cells, HepG2 cells, mouse liver tissue, mouse lung tissue, PC-3 cells. Positive IP detected in HeLa cells. Observed molecular weight by Western-blot: 45-55 kDa
-
Tested applications
ELISA, WB, IHC, IP
-
Species reactivity
Human,Mouse,Rat; other species not tested.
-
Alternative names
GDH antibody; GDH 1 antibody; GDH1 antibody; GLUD antibody; GLUD1 antibody; glutamate dehydrogenase 1 antibody
-
Isotype
Rabbit IgG
-
Preparation
This antibody was obtained by immunization of GLUD1 recombinant protein (Accession Number: NM_005271). Purification method: Antigen affinity purified.
-
Clonality
Polyclonal
-
Formulation
PBS with 0.02% sodium azide and 50% glycerol pH 7.3.
-
Storage instructions
Store at -20℃. DO NOT ALIQUOT
-
Applications
Recommended Dilution:
WB: 1:1000-1:10000
IP: 1:500-1:5000
IHC: 1:20-1:200
-
Validations

HeLa cells were subjected to SDS PAGE followed by western blot with Catalog No:111042(GLUD1 antibody) at dilution of 1:3000

Immunohistochemical of paraffin-embedded human gliomas using Catalog No:111042(GLUD1 antibody) at dilution of 1:100 (under 10x lens)
Immunohistochemical of paraffin-embedded human gliomas using Catalog No:111042(GLUD1 antibody) at dilution of 1:100 (under 40x lens)

IP Result of anti-GLUD1 (IP:Catalog No:111042, 4ug; Detection:Catalog No:111042 1:1000) with HeLa cells lysate 2000ug.
-
Background
Human glutamate dehydrogenase (GDH), an enzyme central to the metabolism of glutamate, is known to exist in housekeeping and nerve tissue-specific isoforms encoded by the GLUD1 and GLUD2 genes, respectively. It catalyses the reversible inter-conversion of glutamate to alpha-ketoglutarate and ammonia, thus interconnecting amino acid and carbohydrate metabolism. GLUD1 might contribute to the formation of specific synapses in the hippocampus such as those formed by the projecting neurons of the entorhinal cortex(PMID: 22138648).
-
References
- Timmer NM, Metaxas A, van der Stelt I, Kluijtmans LA, van Berckel BN, Verbeek MM. Cerebral level of vGlut1 is increased and level of glycine is decreased in TgSwDI mice. Journal of Alzheimer's disease : JAD. 39(1):89-101. 2014.
- Sun L, Song L, Wan Q. cMyc-mediated activation of serine biosynthesis pathway is critical for cancer progression under nutrient deprivation conditions. Cell research. 25(4):429-44. 2015.
- Li CY, Wang YJ, Huang SW, Cheng CS, Wang HC. Replication of the Shrimp Virus WSSV Depends on Glutamate-Driven Anaplerosis. PloS one. 11(1):e0146902. 2016.
Related Products / Services
Please note: All products are "FOR RESEARCH USE ONLY AND ARE NOT INTENDED FOR DIAGNOSTIC OR THERAPEUTIC USE"
